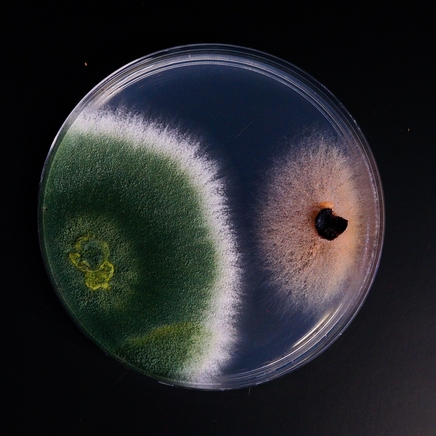
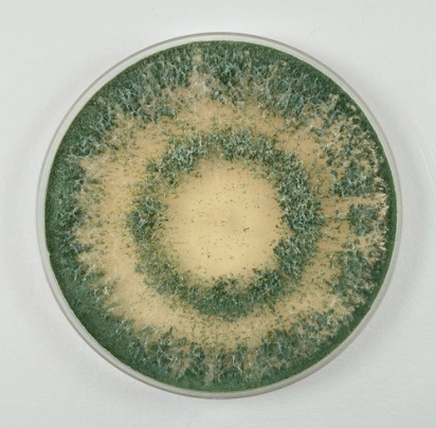
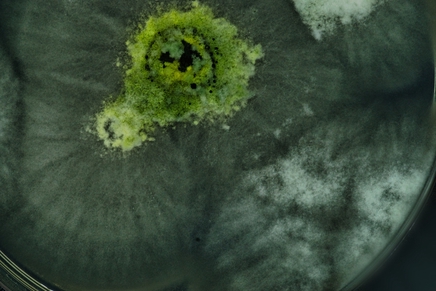

2 янв 2026
Триходерма: какую форму выбрать
В мире биопрепаратов есть средства, которые занимают особое место в аптечках дачников и называются одним обобщающим словом – триходерма. Trichoderma viride, Trichoderma harzianum, Trichoderma lignorum и многие другие – все они подавляют патогены, укрепляют корневую систему растений и повышают урожайность культур. И зачастую садоводы и огородники задаются вопросом: какая из этих разновидностей триходермы эффективнее? Сегодня постараемся ответить на этот резонный вопрос.
Что такое триходерма
Триходерма – это целое семейство полезных почвенных грибков, которые доказали свою эффективность против множества болезней растений. В процессе своего развития эти грибы вырабатывают несколько видов антибиотиков, разрушающих фитопатогены, а также разлагают полисахариды, переводя имеющиеся в почве питательные вещества в легкоусвояемую растениями форму.
Каждый грибок имеет свои особенности и свои преимущества – один лучше стимулирует рост растений, другой лучше справляется с конкретными болезнями, третьему для активной работы нужны особые климатические условия, четвертый предпочитает какие-то определенные культуры и т.д.
Но есть общее свойство: альтернариоз, аскохитоз, белая, серая и корневая гнили, мучнистая и ложная мучнистая роса, фузариоз, фитофтороз, фомоз, гельминтоспориоз, черная ножка и другие грибковые заболевания обходят стороной гряды, обработанные такими препаратами, как Триходермин, Трихоплант, Глиокладин, Трихоцин и др.
Разновидности триходермы

Тrichoderma viride
Самый известный вид – триходерма вериде. Дачники называют ее зеленой – из-за внешнего вида.
Основу составляет спорово-мицелиальная масса гриба Trichoderma veride – не менее 1 млрд спор/г.

Сам гриб выглядит как зелёная плесень с пушистым мицелием, под микроскопом хорошо видны кистевидные структуры с зелеными спорами.
Препараты на основе грибка выпускаются в форме порошка.
Основные области применения Trichoderma viride:
- обработка семян перед посевом для повышения всхожести и защиты от болезней;
- внесение в почву для подавления патогенной микрофлоры и улучшения структуры;
- полив под корень для защиты растений и стимуляции корневой системы;
- обработка овощей и фруктов, закладываемых на хранение;
- восстановление почв, загрязненных химическими пестицидами;
- разложение органических остатков в компостах.

Тrichoderma harzianum
Триходерма харзианум по своему действию схожа с Вериде и считается ее лучшим союзником.
Так же широко применяется в сельском хозяйстве в качестве биологического фунгицида и стимулятора роста растений.
Выделяет еще больше природных антибиотиков, способствующих росту растений. И с еще большей скоростью поедает патогенные грибы.
Но самое главное – образовывает микоризные связи с растениями.
Эта триходерма используется для производства ферментов.
Штаммы данного вида триходермы устойчивы к более низким температурам и широко распространены в почвах на различных континентах. Они колонизируют поверхности корней и листьев и вызывают системную индуцированную устойчивость растений.
Но эффективность этого препарата выше при профилактическом применении, чем при лечении уже развитых инфекций.

Тrichoderma lignorum
Триходерма лигнорум рекомендуется для защиты растений от широкого спектра грибных и бактериальных заболеваний. Она эффективна против 60 видов болезнетворных грибков, активно подавляет развитие корневых гнилей – в частности, черной ножки.
Но для поддержания эффекта требует регулярного внесения (в теплицах не реже, чем раз в три недели, а в открытом грунте – раз в месяц). И может быть менее результативна в сильно зараженных почвах.
Также ее можно использовать для переработки компостов, в которые закладывались опилки, древесина.

Тrichoderma asprellum
Триходерма асперeллум – очень сильный грибок, полностью уничтожает такие опасные инфекции, как фузариоз и ботритис (серую гниль земляники). Микопаразитаный эффект наступает очень быстро.
И подавляется развитие таких болезней как аскохитоз, церкоспороз, спорынья, альтернариоз, вертициллез, корневые гнили, кладоспориоз на различных культурах.
Особенно показана для применения на ягодных кустарниках и землянике.
Фунгициды на основе Trichoderma asperellum рекомендуется использовать для чередования препаратов с другими действующими веществами фунгицидной активности – чтоб избежать возникновения устоячивых популяций фитопатогенных организмов.

Trichoderma longbrachiatum
Встречается во всем мире, но в основном в более теплом климате.
Это особый вид триходермы, который обладает энтомопатогенным эффектом, поэтому может использоваться как природный фунгицид и инсектицид одновременно.
Эта триходерма способна разрушать хитин, а значит – уничтожать насекомых, это делает ее инсектицидом и фунгицидом одновременно.
Trichoderma atroviride
Триходерма атровириде (черно-зеленая триходерма) – наиболее активна в подавлении патогенного грибка, уничтожающего урожай пасленовых.
Поэтому дачники ее стараются ее вносить под томаты один-два раза в месяц на протяжении всей вегетации.
Этот гриб улучшает усвоение растениями азота и фосфора, способствуя более интенсивному росту культур. Он также стимулирует развитие корней, повышает способность растений поглощать питательные вещества из почвы в стрессовых условиях.
Кроме того, триходерма атровириде оказывает прямое воздействие на качество плодов.

Trichoderma citrinum
Триходерма цитринум (лимонная или желтая) – способна активно разлагать еловые опилки, а также выживать в условиях низкого рН.
В садоводстве используется на кислых почвах и как компонент микоризы для ацидофиллов.
Садоводы рекомендуют ее добавлять ее в почвосмеси для вересков, голубики и прочих ацидофилов – образует с ними микоризные связи.
Есть еще и другие виды триходермы, которые широко не применяются в огородничестве:
- Trichoderma hamatum – обладает антибактериальной активностью в отношении возбудителя сибирской язвы в почве.
- Trichoderma reesei – перерабатывает целлюлозу, поэтому ее используют для производства джинсов с эффектом "варенки".
- Trichoderma koningii – продуцирует метаболиты, заживляющие раны корня и подавляющие корневые гнили.
- Trichoderma pseudokoningii – супермикопаразит, который быстро перерабатывает все, что попадает в его зону.
Как применять триходерму

- Триходерма способна развиваться лишь при температуре от 5 до 35°С – использовать ее в холодное время года бессмысленно.
Обработать семяна
Семена замачивают в растворе триходермы, приготовленном по инструкции с упаковки конкретного препарата. И выдерживают в течение часа.
Как показывает практика, обработанные триходермой семена лучше всходят и реже страдают от грибковых заболеваний, особенно в стадии рассады.
Обработать рассаду
Это можно делать перед высадкой рассады на постоянное место.
Емкость с рассадой проливают питательным раствором триходермы (по инструкции).
Можно просто погрузить рассаду в раствор триходермы на 30 минут, а затем высадить.
Обработать почву
Весной (за неделю до посадок и посева семян) на ведро воды берут 50 мл препарата и поливают полученной смесью 10 кв.м почвы.
Осенью рабочий раствор должен быть более концентрированным: в 10 л воды разводят 150 мл средства. И поливают почву сразу после уборки урожая или при заделывании в грунт растительных остатков.
Обработать растения
75-100 мл препарата разводят в 10 л воды и проливают посадки под корень каждые 10-12 дней до того момента, пока признаки болезни не исчезнут.
- Триходерма для лечения запущенных стадий заболеваний не годится! В таких случаях дачники применяют химикаты. А потому уже через недели две обрабатывают растения препаратами триходермы, которые уже "доедают" ослабленные фитопатогены.
Основные условия применения триходермы
- Разводить препараты триходермы нельзя хлорированной водой!
Использовать лучше всего отстоянную воду или воду из колодца, пруда.
Вносить препараты в почву необходимо регулярно, а после этого грунт нужно мульчировать
Грунт для рассады заселяют триходермой заранее – чтобы за несколько недель гриб мог разрастись.
- Триходерму не вносят одновременно с химическими фунгицидами и с препаратами на основе сенной палочки.
А вот совместное внесение удобрений грибку не вредит и его рост не подавляет.
Триходерма – это не просто биофунгицид, а целая система природных помощников. Универсальной формы нет, выбор зависит от того, что для вас важнее – профилактика болезней или стимуляция роста растений. Поэтому советуем комбинировать разные виды триходермы, создавая комплексную защиту и поддержку растений.